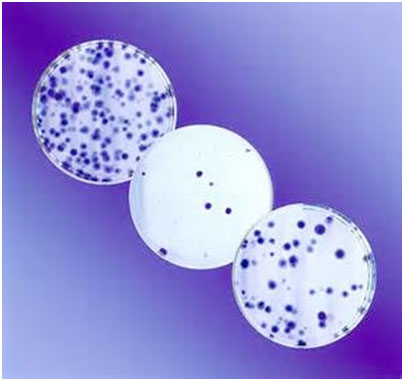

Tags: Società
UOMO E ANIMALE
Perché non parli?
- di: Francesco Mauro
- Il rapporto fra uomo e animali può essere descritto attraverso le sue caratteristiche etiche, religiose, lavorative, produttive e alimentari, con particolare attenzione ai problemi rilevanti del vegetarianismo e della sperimentazione animale. Emerge così l’esistenza di un dibattito in corso che recentemente tende ad essere aspro, divisivo e intollerante, peraltro di difficile soluzione e foriero di ulteriori problemi.

Giochi con i tori. Dipinto, Palazzo di Cnosso, Creta, 1600 a.c.
Poi Iddio disse: Produca la terra erba minuta, erbe che facciano seme, secondo la loro specie, ed alberi che portano frutta, il cui seme è in esso … Producano le acque copiosamente rettili, e volino gli uccelli sopra la terra e per la distesa del cielo … produca la terra animali viventi … bestie domestiche, rettili e fiere della terra, secondo le loro specie … e Iddio vide che ciò era buono …e Adamo pose nome ad ogni animale domestico, ed agli uccelli del cielo, ed ad ogni fiera della campagna …
(Genesi)
Una storia esemplare.
Il problema del rapporto uomo-animale sembra essere entrato in Italia in una fase nuova, caratterizzato da un dibattito sempre più acceso tra posizioni che si irrigidiscono. L’impressione appare confermata dall’attenzione della stampa e dei media. Basta scorrere le notizie in tal senso degli ultimi due mesi del 2013: “Sit-in vegano al Pantheon contro il consumo di carne” (1 novembre); “Blitz animalista a Milano contro la Moncler per l’uso dei piumini di oca” (4 novembre); diverse proteste animaliste per le condizioni dei cani in Romania, per l’uso alimentare dei gatti in Cina e la morte di un cane in Toscana (4-6 novembre); “Stella McCarteny a Milano contro l’uso delle pellicce” (27 novembre); manifestazione a Roma con cadaveri di animali da cortile (9 dicembre); con l’avvicinarsi del Natale è cominciata l’ormai solita campagna contro i circhi che impiegano animali.
Il 27 dicembre scoppia sulla stampa il caso di Caterina Simonsen, una studentessa di veterinaria di Padova, vegetariana, che soffre di 4 malattie genetiche rare (così definite le malattie che nella popolazione europea hanno una prevalenza inferiore alla soglia dello 0,05), tra cui una immuno-deficienza primaria e il deficit di alfa-1-antitripsina, che la espongono facilmente ad infezioni e la obbligano a usare un respiratore per gran parte della giornata, attualmente ricoverata in ospedale per una polmonite. La ragazza pubblica su Facebook il suo appoggio alla ricerca, che l’ha tenuta in vita: “Ho 25 anni grazie alla vera ricerca, che include la sperimentazione animale. Senza la ricerca sarei morta a 9 anni. Mi avete regalato un futuro”. In 24 ore, la sua dichiarazione riceve 2.690 condivisioni e 13.893 “mi piace”, ma anche una pioggia di insulti tra cui circa 500 commenti offensivi e 30 auguri di morte da parte di animalisti. La ragazza chiarisce che i farmaci che usa sono stati sviluppati usando il minimo indispensabile di sperimentazione animale, secondo le regole della UE e quelle nazionali, permessa dalla normativa e diversa dalla vivisezione. Ma le proteste e gli insulti non si fermano; la ragazza riceve la solidarietà di molti clinici, ricercatori e politici (persino Matteo Renzi). Sulla questione interviene anche Susanna Penco, una biologa ricercatrice dell’Università di Genova, malata di sclerosi multipla, membro dell’Associazione Diritti Animali e Ambiente, di cui è presidente l’on. Michela Vittoria Brambilla (FI), che condanna di questa vicenda le “strumentalizzazioni” e rilancia il ricorso a “metodi alternativi” (sulla questione torneremo più sotto).
Elementi di normativa.
Quello che emerge è la presenza ormai di un clima di confronto aspro, spesso intollerante, sulle questioni riguardanti il rapporto fra uomo e animali che tocca ormai molti settori della vita umana. La situazione è complicata anche a livello normativo, dato che si sono mossi sia il Parlamento che il Governo. Il Parlamento ha approvato il 3 marzo 2013 una nuova normativa che prevede il divieto della conduzione su animali “degli esperimenti concernenti la tossicità da uso ripetuto, la tossicità riproduttiva e la tossicocinetica”. Questa legge è seguita al “divieto di sperimentazione su ingredienti o combinazioni di ingredienti” entrato in vigore l’11 Marzo 2009, che si riferisce però solo certi esperimenti.
L’attuale divieto riguarda anche la commercializzazione dei prodotti cosmetici testati su animali, permettendo quindi la sola vendita di prodotti cosiddetti “cruelty-free”. La scopo di fondo del divieto è quello di arginare l’utilizzo della sperimentazione animale in campi di non assoluta necessità per l’uomo, quali la cosmetica. Si tratta della principale novità introdotta dalla direttiva 2003/15/CE, recepita nel nostro ordinamento con il decreto legislativo n. 50/2005, ossia la fissazione di un quadro normativo volto alla graduale soppressione della sperimentazione sugli animali. La posizione europea però prendeva atto che questa pratica sperimentale non poteva essere completamente sostituita da un metodo alterativo se non per prodotti e loro componenti già conosciuti e testati.
In questo quadro, il Parlamenti aveva impegnato il Governo e le istituzioni tecniche a sviluppare metodi sostitutivi alla sperimentazione su esseri “senzienti”. Ma recentemente, allo scopo di trovare un difficile compromesso fra due fronti e tra animalisti e la vasta maggioranza dei ricercatori, il Consiglio dei Ministri ha reputato opportuno introdurre una moratoria di tre anni per i settori più divisivi della proposta normativa. C’è anche il pericolo che una normativa nazionale più restrittiva di quella europea esponga l’Italia ad un’ennesima procedura di infrazione.
Comunque, a nostro avviso, in questo caso il metodo italico del rimando potrebbe non funzionare, aprendo una crisi di difficile soluzione e con possibili ripercussioni incontrollate sull’economia e l’ecologia del paese, sulla sua stessa storia culturale e sulle prospettive della sostenibilità.
Il comportamento di Homo sapiens sapiens.
Un primo punto da considerare nel rapporto uomo-animali è la questione alimentare. L’uomo è considerato una specie onnivora: nei mammiferi le specie onnivore sono una minoranza rispetto agli erbivori e ai carnivori (ad esempio, oltre l’uomo, gli altri primati e il maiale; alcuni sono in realtà dei carnivori che incrementano il nutrimento con una dieta onnivora, tipicamente gli orsi, o un comportamento da “scavenger”, ossia da raccoglitore di rifiuti organici: insettivori come ricci e istrici, roditori come topi e ratti, canidi come cani e volpi, altri carnivori come procioni e puzzole). La condizione di onnivoro potrebbe far parte di un certo percorso evolutivo ma in genere non ha valore sistematico indicativo. Inoltre, tale condizione si modifica, per quel che riguarda il rapporto fra i tessuti animali e vegetali consumati (ed anche tessuti fungini, algali e minerali), nel corso della vita della specie, della popolazione e dell’individuo.
Escludendo alcune interpretazioni ideologiche o esoteriche, esistono numerose indicazioni che Homo sapiens sapiens, cioè l’uomo moderno, sia stato un onnivoro mangiatore di carne. Alla fine dell’ultima glaciazione, nella fase finale del Magdaleniano (14.000-8.500 a.c.), l’uomo ha sviluppato lance con la punta d’osso, fiocine di corna lavorate ed i primi archi e frecce, tutti strumenti tipici di cacciatori-raccoglitori. L’arte delle caverne (alla base dei Monti Cantabrici, dei Pirenei, Massiccio Centrale ed Alpi Marittime) dipinge figure di animali chiaramente utilizzati dall’uomo: bisonti, cervi, cavalli, mammouth e mastodonti, orsi delle caverne, leoni; è evidente l’uso di lampade che impiegavano grasso animale come combustibile. Il cambiamento climatico collegato alla fine della glaciazione, con la ritirata dei ghiacci e l’innalzamento consistente del livello del mare resero più vulnerabile la fauna adattata alla glaciazione, soprattutto i grandi erbivori non-ruminanti, con conseguente aumento delle attività di caccia. Il rapporto con gli animali si modificò ulteriormente con l’invenzione dell’agricoltura e della domesticazione (degli animali, delle piante e dei mircroorganismi): dopo il cane (almeno dal 15.000 a.c.), grandi ruminanti (capra, pecora, bovini, fra i 10.000 e l’8.000 a.c.) in contemporanea con diverse specie di cereali e di legumi, il maiale (8.000 a.c.), gli animali da cortile (dal 6.000 a.c.), gli equini (4.000-3.000 a.c.). Tutto ciò portò senza dubbio all’aumento del consumo carneo e dello sfruttamento animale per il trasporto, le pratiche agricole, la caccia e la guerra.
Il percorso degli animali della storia umana può essere ricostruito. Il primo grande cambiamento è l’affiancamento alla caccia dell’allevamento e delle formazione delle greggi permesso dalla domesticazione. Emerge quindi la sacralizzazione dell’animale con l’elaborazione delle credenze totemiche e addirittura della trasmigrazione dell’anima. La ritualità porta però anche ad ulteriore sfruttamento come nel caso dei sacrifici religiosi e dei giochi taurini del Mediterraneo antico. Con le invasioni barbariche comincia il periodo delle grandi migrazioni dei cavalieri della steppa euroasiatica. Il ruolo del cavallo e dei bovini si ripete nella colonizzazione delle Americhe (dal XV secolo) da parte degli europei che ricevono in cambio derrate oggi essenziali oppure lo spazio da dedicare all’agricoltura. Il ruolo degli animali cambia ancora con la scienza moderna: Linneo classifica gli esseri viventi (1735), Galvani conduce sulla rana gli esperimenti sull’elettricità (1790), Darwin sviluppa la teoria dell’evoluzione, nasce la genetica moderna (1859), la conoscenza della struttura del DNA da parte di Watson e Crick (1953) aprirà la strada alle biotecnologie moderne.
Religioni e regole alimentari.
Il primo movimento che ha posto seri ostacoli al consumo di carne ed ha indicato dei limiti al trattamento degli animali è avvenuto con la comparsa delle regole alimentari religiose, anche se esse oscillano tra il divieto al consumo di certe specie e le normative per una corretta macellazione e manipolazione. Brevemente:
- Ebraismo / kosher (casherut = adeguatezza): un insieme di regole molto complesso e preciso, secondo prescrizioni che vengono fatte risalire alla legge mosaica, sul modo di macellazione, le specie che non possono essere consumate (tra cui il maiale e i crostacei), le parti animali che non possono essere mangiate, la proibizione di certe combinazioni di cibi, prescrizioni per certi giorni particolari, uno stretto controllo con certificazione religiosa sul rispetto delle regole.
- Cristianesimo: il cristianesimo cattolico comprendeva l’astensione dal consumo di carne (ma non di pesce o uova) il venerdì, e di digiuni di varia entità in particolari periodi o giorni (le quattro tempora di Avvento, Quaresima, Pentecoste e Settembre; le vigilie più importanti di Natale, Pasqua e Pentecoste); il cristianesimo ortodosso prevede in giorni diversi da quello cattolico vari gradi di astensione o digiuno che possono arrivare a comprendere pesce, uova, latte e prodotti caseari, alcool e olio d’oliva; nel cristianesimo protestante alcune denominazioni (battisti, anabattisti) proibiscono l’alcool ed altre (avventisti e storicamente i Catari) sono di fatto vegetariane.
- Islam / halal (= lecito): severamente proibito l’alcool e il maiale, altre regole minori simili alla casherut, uno stretto controllo con certificazione religiosa sul rispetto delle regole.
- Induismo: dieta lacto-vegetariana, la vacca è animale sacro, molti i giorni di digiuno con dieta solo vegetale, i brahmini applicano restrizioni su chi può preparare il loro cibo e su come viene conservato.
- Buddismo/ ahisma (= non far male): non ci sono regole ma la maggioranza dei buddisti segue una dieta lacto-vegetariana; ulteriori restrizioni per i monaci che hanno giorni di digiuno e la prescrizione di non assumere cibo solido dopo mezzogiorno.
- Jainismo / ahisma (non-violenza): come il buddismo con in più la proibizione di consumare radici per non uccidere la pianta, alcune pratiche di digiuno riservate alle donne.
La tesi che queste regole religiose abbiano un’origine igienico-sanitaria viene periodicamente avanzata, soprattutto nei riguardi della carne di maiale. Per gli ebrei, Dio dice a Mosè e ad Aronne: "Questi sono gli animali che potrete mangiare fra tutte le bestie che sono sulla terra. Potrete mangiare d'ogni quadrupede che ha l'unghia bipartita, divisa da una fessura, e che rumina. Ma fra i ruminanti e gli animali che hanno l'unghia divisa, non mangerete i seguenti: il cammello, perché rumina, ma non ha l'unghia divisa, lo considererete immondo;… ; il porco, perché ha l'unghia bipartita da una fessura, ma non rumina, lo considererete immondo. Non mangerete la loro carne e non toccherete i loro cadaveri; li considererete immondi." (Levitico XI, 7). Per i musulmani, nel terzo verso della sura della Mensa Imbandita, il Corano (5, 3) recita: "Vi sono stati vietati: la carne di bestia morta, il sangue, la carne di porco, la carne di bestia su cui è stato invocato un nome diverso da quello di Allah, la bestia soffocata, o ammazzata, o morta per precipitazione o per cornata, o quella uccisa da un predatore, essendo ancora viva, voi possiate scannarla (e farne uscire tutto il sangue), e carne di bestia immolata su pietra. Però, se qualcuno di voi, costretto dalla fame e senza spirito di trasgressione, mangia per sopravvivere. Ebbene, in verità Allah è Perdonatore Clementissimo". Rispetto al Levitico, il precetto coranico pone sullo stesso piano l'impurità della carne di porco e quella degli animali macellati invocando altro nome che quello di Allah. Il divieto appare meno drastico e persino tollerante per i trasgressori che agiscono in stato di necessità; in Malesia e Indocina, dove l'habitat e la culture sono totalmente diversi, la dieta carnea a base suina convive con il credo musulmano. Per i cristiani, risulta chiara la I Lettera di Paolo a Timoteo: “ … negli ultimi tempi alcuni si allontaneranno dalla fede, dando retta a … impostori … costoro vieteranno il matrimonio, imporranno di astenersi da alcuni cibi che Dio ha creato per essere mangiati con rendimento di grazie dai fedeli e da quanti conoscono la verità … tutto ciò che è stato creato da Dio è buono e nulla è da scartarsi, quando lo si prende con rendimento di grazie, perché esso viene santificato dalla parola di Dio e dalla preghiera". Sulla scorta dell'insegnamento paolino, il cristianesimo ha abbandonato ogni proibizione alimentare. L’impressione che se ne trae è che queste norme, nel caso delle tre religioni abramitiche monoteiste, abbiano un’origine prettamente confessionale e ben poco di regolamentazione igienica, esprimendo semmai aspirazioni a marcare il valore dell’identità culturale.
Storicamente, il vegetarianismo religioso è stato presente anche in Occidente e negli stati dell’Ellenismo, come evidente dalle elaborazioni in tal senso del mito greco dell’”età dell’oro”, del culto misterico di Orfeo, dell’insegnamento di Pitagora, del Manicheismo e dell’insegnamento di vari filosofi naturalisti, platonici e neoplatonici.
Il vegetarianismo nell’Occidente moderno.
Ma la grande crescita del vegetarianismo avviene, fra molte ispirazioni orientali o orientaleggianti, in Occidente in età moderna. Da questa crescita nasce lo stesso termine di vegetariano, un neologismo diffusosi agli inizi del XX secolo, con radice dal latino vegetus (sano, attivo, vigoroso). Nel vegetarianismo si possono distinguere diverse pratiche alimentari, che si manifestano in abitudini dietetiche che, sebbene possano essere anche molto differenti l'una dall'altra, sono tutte accomunate dalla rigorosa esclusione della carne di qualsiasi animale:
- lacto-ovo-vegetarianismo (ammette i prodotti animali indiretti),
- lacto-vegetarianismo (come il precedente ma che esclude le uova) presente nella tradizione asiatico-indiana (diete sattva o yogiche),
- ovo-vegetarianismo (come il primo della lista ma escludendo latte e derivati),
- vegetarismo o veganismo dietetico (ammette qualche alimento di origine animale),
- crudismo vegano (società fondata nel 1944, ammette esclusivamente alimenti di origine vegetale ma non sottoposti a trattamenti termici oltre i 40o, ammessa la essiccazione),
- fruttarismo (a base di frutta fresca, secca e semi).
Normalmente, i vegetariani che includono l'alimentazione in una più vasta scelta etica evitano anche alimenti che comprendano tra gli ingredienti ridotte quantità di cibi animali, per esempio prodotti da forno preparati con lo strutto (o sugna), pasta all’uovo e brodo di carne.
Storicamente, i primi segni dei vegetariani moderni si hanno in Inghilterra nel XVI secolo. Nel Settecento il vegetarianismo inizia ad essere un argomento sostenuto e diffuso anche da alcuni medici, in nome della salute e delle caratteristiche dell'anatomia e della fisiologia umana che, a partire dall'apparato digerente, dalla dentatura e dalle mani, dimostrerebbero la natura vegetariana dell’uomo. In questo periodo, Voltaire torna sulla questione della crudeltà verso gli animali e del vegetarianismo in numerose opere, mentre in Inghilterra, soprattutto dalla fine del Settecento, si parla sempre più di vegetarianismo e si susseguono alcune pubblicazioni importanti. In Inghilterra, nel 1847, viene fondata la Vegetarian Society, seguita da società analoghe in altri paesi: Germania (1867), Francia (verso la fine dell’Ottocento), Italia (a metà del secolo scorso). Nel frattempo, nel 1908, viene fondata l’International Vegetarian Union e, nel 1944, la Vegan Society.
Nel 1975 viene pubblicato Animal Liberation del filosofo australiano Peter Singer, la prima opera contemporanea sui diritti animali con ampia diffusione internazionale: Singer fornisce argomenti razionali contro il pregiudizio e la discriminazione di specie (specismo) e definisce il vegetarianismo come un obbligo etico nel rispetto della vita degli animali, sostenendo che il piacere del gusto offerto dalla carne sia irrilevante a fronte dei maltrattamenti subiti dall'animale nell'allevamento e della sua uccisione.
Nel 1983, il filosofo americano Tom Regan, con Animal Rights, criticando e rigettando le posizioni di Singer, mira a dimostrare che la vita animale ha valore intrinseco e che quindi gli animali devono essere trattati non come mezzi ma come fini: il vegetarianismo, pertanto, si configura come una doverosa e logica conseguenza del riconoscimento del diritto di vivere all'animale.
Comunque, le ragioni che comunemente sono alla base di una scelta vegetariana includono motivazioni etiche di rispetto per la vita animale, principi religiosi, attenzione per la salute e preoccupazione per l'ambiente. Tali motivazioni non sono tutte necessariamente adottate insieme, anche se spesso due o più di loro possono coesistere negli stessi soggetti, ma solitamente una prevale sulle altre.
Di particolare interesse sono i dati biomedici riguardanti la pratica vegetariana. La crescente evidenza della relazione tra consumo di cibi animali – e in particolare di carni rosse (manzo, maiale, agnello e capra) e carni conservate (carni affumicate, stagionate o salate o con l'aggiunta di conservanti chimici) – e rischio di malattie croniche (cardiovascolari, cancro e diabete), la frequente diffusione di malattie virali e parassitarie negli animali allevati, il crescente uso di antibiotici e altri farmaci negli allevamenti, da una parte, e i numerosi studi sui benefici dei cibi vegetali in generale, e sulle diete vegetariane in particolare, dall'altra, hanno contribuito negli ultimi decenni alla diffusione delle diete vegetariane presso le popolazioni dei paesi più ricchi. Rispetto ai non-vegetariani, tra i vegetariani è stata osservata una minore incidenza di alcune delle più diffuse patologie dei paesi ricchi: sovrappeso e obesità (in particolare tra i vegani), cardiopatia ischemica, alcuni tipi di tumore (prostata, colon-retto, stomaco, vescica, linfoma non-Hodgkin, mieloma multiplo), ipertensione arteriosa (specialmente nei vegani) e Alzheimer; e per alcune di queste patologie (cadiovascolari, prostata, artrite reumatoide, asma) le diete vegane sono state usate a scopo terapeutico.
Schematizzando, due grandi categorie di motivi possono essere addotti a favore del vegetarismo: quelli a carattere religioso e quelli a carattere igienico-sanitario. A queste si può aggiungere una terza categoria, quella della sostenibilità ambientale, soprattutto per quel che riguarda la zootecnia di produzione della carne. Nella seconda metà del Novecento, il consumo globale di carne è aumentato di 5 volte, passando da 45 milioni di tonnellate all'anno nel 1950 a 233 milioni di tonnellate all'anno nel 2000; secondo la FAO (2007), in tutto il mondo ogni anno vengono macellati, per fini alimentari, circa 56 miliardi di animali, esclusi pesci e altri animali marini. La zootecnia globale è ritenuta un fattore chiave nell'uso di risorse alimentari (granaglie) e idriche, inquinamento delle acque, uso dei suoli, deforestazione, sottrazione di spazio e risorse alla biodiversità naturale. Per quanto riguarda il consumo idrico, è stato osservato che la produzione di cibo per un giorno per una persona che segue una dieta a base di cibi animali necessita di 15.100 litri di acqua, 4.500 per chi segue una dieta lacto-ovo-vegetariana, mentre ne sono sufficienti solo 1.100 per chi segue una dieta vegana.
Il vegetarianismo vanta una certa diffusione: 40% della popolazione in India grazie alla lunga tradizione in proposito; negli USA circa il 5% della popolazione adulta segue in modo regolare una dieta lacto-ovo-vegetariana e circa la metà è vegano, circa il 3% dei bambini e degli adolescenti tra gli 8 e i 18 anni è lacto-ovo-vegetariano e quasi l'1% è vegano. Altri paesi occidentali presentano percentuali ancora maggiori, ad esempio la Germania, dove oltre il 7% della popolazione è vegetariano, o anche l'Italia, con il 6% di vegetariani (di cui l'1,1% vegano).
Per i diritti degli animali.
Grande rilevanza nel dibattito sul rapporto uomo-animali hanno avuto le associazione ed i movimenti legati alla difesa dei diritti degli animali in quanto tali e per tutti gli aspetti in cui la loro vita può estrinsecarsi: da una esistenza dignitosa e priva di maltrattamenti (specialmente per i “pet” da compagnia, per gli animali da lavoro e da produzione, ecc.) all’abolizione dell’uso del cuoio e della pelle o pellicce, dal randagismo al commercio, dall’assistenza sanitaria alla sperimentazione animale, ecc. Di questi problemi se ne sono occupati dapprima i movimenti protezionistici storici:
- in Italia, l’Ente Nazionale Protezione Animali, fondato nel 1871 come Reale Società per la Protezione degli Animali per iniziativa di un gruppo di nobildonne torinesi su esplicita richiesta di Garibaldi e della contessa inglese Anna Winter; divenuto ente morale “nazionale fascista” nel 1938 ed ente di diritto pubblico con personalità giuridica nel 1954, privatizzato nel 1979, è tuttora attivo e ben conosciuto per la sua presenza sul campo con le guardie zoofile e le iniziative pratiche di rifugio e protezione degli animali;
- associazioni simili con caratteristiche di servizio sono nei paesi di lingua inglese le cosiddette “humane society”: la più antica in Inghilterra nel 1776, e poi in Australia (fondata nel 1871 nel Victoria), Canada (1869), Nuova Zelanda (1882), Stati Uniti (dal 1954, ma le società di molti dei singoli stati risalgono all’Ottocento) – riunite in un rete internazionale.
Appartiene a questo filone, più sul versante conservazionista:
- l’associazione a rete del WWF, fondato nel 1961 come World Wildlife Fund, dal 1986 ha cambiato il nome in World Wide Fund for Nature a marcare la tendenza, forte in alcuni paesi tra cui l’Italia, verso l’associazionismo ecologista.
Due associazioni internazionali vanno anche ricordate su questo fronte:
- l’IUCR (International Union for the Conservation of Nature), fondata nel 1948, tradizionalmente impegnata nel conservazionismo scientifico, mantiene e aggiorna la lista delle specie minacciate di estinzione, ma di recente ha posto l’accento sul livello ecosistemico;
- nel settore specifico degli uccelli, BirdLIfe International, fondato nel 1922 come comitato di lobby, rilanciato come rete nel 1993 (da non confondere con Birds International Inc. che opera nel campo dell’avicoltura).
In teoria, dovrebbero appartenere a questo tipo di associazioni Greenpeace (in realtà dedita ad azioni esemplari su diversi settori ambientali), Friends of the Earth (una storica associazione ambientalista) e Legambiente (esiste solo come realtà italiana). Sul piano nazionale sono da ricordare in settori specifici: la LIPU (Lega Italiana Protezione Uccelli, 1965, partner di BirdLife International) e Marevivo (1985).
Lo specifico problema del trattamento degli animali e della sperimentazione su di essi ha visto un fiorire di associazioni animaliste militanti:
- la LAV (Lega Anti Vivisezione, dal 1977),
- il capitolo italiano di Animal Equality (dal 2006), focalizzata sull’anti-specismo,
- molte altre associazioni animaliste o dichiaratamente tali, recentemente riunite nella Federazione Italiana Associazioni Diritti Animali e Ambiente.
Vi sono infine:
- la PETA (People for the Ethical Treatment of Animals) fondata nel 1980 con un programma ispirato dal libro di Peter Singer e presente in vari paesi: porta avanti la lotta mediante manifestazioni e boicottaggi contro l’allevamento intensivo, la vivisezione e la sperimentazione animale, la pellicceria e gli animali da divertimento (ma non disdegnando obiettivi difficili, come l’opposizione alla disinfestazione dei ratti);
- l’ALF (Animal Liberation Front), una associazione forse ancora più militante, fondata nel 1976, che dichiara bellicosamente di operare con nuclei clandestini, anche se non violenti (ma solo nel senso che si cerca di evitare danni ad esseri viventi), per liberare animali e impedire il funzionamento di gabbie, recinti, laboratori, impianti e uffici.
Sia ALF che PETA vengono accusate da diversi governi di essere infiltrate da terroristi o di essere disponibili ad azioni di terrorismo o di praticare una forma non-convenzionale di terrorismo.
Alcune considerazioni.
Il dibattito sul rapporto uomo-animali e sui diritti animali si sta dimostrando dirompente e divisivo. Esso appartiene evidentemente alla categoria delle tematiche “di coscienza” che sono note da tempo ma recentemente hanno assunto carattere di emergenza sia per la percezione che esse ingenerano nella pubblica opinione che per le implicazioni politiche comprese quelle della “politica politicante”. In altre parole, essa appartiene, mutatis mutandis, al gruppo di tematiche come l’eutanasia, la fecondazione assistita, la libertà di cura e, soprattutto, l’aborto, e a cui tutti sono sensibili in un modo o nell’altro. Come nel caso dell’aborto, infatti, la questione animale viene vista da taluni in un modo tale che altri considerano inaccettabile e viceversa. Più precisamente, gli uni considerano l’uccisione di un animale lecita, opportuna, se non necessaria; gli altri considerano tale atto come un crimine grave, che comporta i mezzi più drastici e violenti per evitare che venga commesso.
L’introduzione della questione dei diritti degli animali nel novero dei problemi etici di cui si occupa oggi la politica può a sua volta aver peggiorato il quadro per quel che riguarda la mancata accettazione reciproca. Alcuni settori protestanti e cattolici antiabortisti possono esprimere la convinzione che la creazione divina degli animali (ma perchè non delle piante?) ed il potere dato ad Adamo di assegnare loro i nomi dia all’uomo il diritto di disporne a piacimento. Viceversa, esiste pure il caso in cui la posizione pro-animali diventa pro-vita e quindi anche anti-aborto. E’ da notare che la Chiesa Cattolica, come nel caso molto più noto dell’evoluzionismo, ha preso una posizione molto prudente (lasciando ad alcune chiese protestanti un uso ad ogni costo del testo biblico): “Concern for exercising proper stewardship over animals ought to be a balanced part of a broader concern to avoid exploiting the vulnerable … The Catholic Church recognizes how man holds a special place in creation, while remaining an integral part of that creation” (US National Catholic Bioethics Center).
Purtroppo, una tematica così importante, con queste caratteristiche simili a quelle di altri grandi temi etici, offre spazio al mancato riconoscimento reciproco (non solo delle ragioni ma della legittimità o dell’esistenza stessa), all’intolleranza e all’esercizio, per ora marginale e in qualche modo controllato e represso, della violenza. L’impressione è che il peso relativo di questa tematica stia aumentando e che possa costituire l’innesco di fattori di instabilità fra paesi e all’interno di paesi. Un dato positivo è dato dal fatto che le religioni, o una stragrande maggioranza di esse, abbiano da tempo smesso di concorrere a questo capitolo dell’intolleranza, ma il loro posto è stato preso da fonti di settarismo meno forti sul piano numerico ma rafforzate dagli estremismi e da fattori concomitanti.
Vi è anche da considerare che un atteggiamento proibizionista (a favore dei diritti animali) in crescita e capace di condizionare la politica potrebbe portare ad effetti economici pesanti e congiunturali: si pensi ad una ristrutturazione del sistema produttivo agro-alimentare in termini vegetariani (magari collegato a altri fattori nello stesso settore, come i metodi di coltivazione “biologica”). Le implicazioni politiche e financo geopolitiche sono evidenti.
Effetti ugualmente rilevanti si potrebbero avere nel settore farmaceutico, biotecnologico e biomedico – e ovviamente anche nel settore cosmetico, che alcuni tendono però a considerare più “sacrificabile” - nel caso di una proibizione dell’uso di animali a fini di ricerca o di controllo. E’ da notare che l’opinione pubblica e i media hanno spesso una visione erronea dell’uso di animali nella ricerca biomedica: con l’eccezione di rare ricerche di chirurgia sperimentale, la vivisezione e gli interventi anatomici sono da lungo tempo scomparsi, non tanto per considerazioni etiche quanto per riconosciuta inutilità di fronte al progredire delle conoscenze. Le caratteristiche della sperimentazione animale che la rendono interessante al ricercatore sono altre: principalmente, la possibilità di avere popolazioni di individui omogenee (per età, patrimonio genetico, patologia) e statisticamente significative; e la possibilità di studiare in vivo i meccanismi d’azione (di farmaci, composti, inquinanti, ecc.), dove il problema è l’andamento del fenomeno studiato, non i suoi valori quantitativi. Peraltro, una potente spinta in direzione della diminuzione e ottimizzazione dell’uso di animali nella sperimentazione è stata fornita da un problema economico, e cioè dal vertiginoso aumento dei costi degli animali da laboratorio man mano che aumentavano le esigenze di caratterizzarne geneticamente le popolazioni, aumentare le garanzie di qualità e trasferire la produzione e la stabulazione degli animali da impianti gestiti in proprio ad aziende specializzate: come risultato, alcuni grandi enti hanno cercato di mantenere gli stabulari in attività, e si è cercato di diminuire al massimo il consumo. Un certo decremento del consumo di animali che si è visto negli ultimi tempi è probabilmente dovuto sia al tentativo di contenere questi costi, sia agli effetti della crisi finanziaria sul finanziamento della ricerca, sia all’esaurimento di alcuni filoni di indagine. Più in generale, l’economia rappresenta un fattore assai importante che può andare in una direzione o nell’altra per alcuni settori: la sperimentazione animale, l’agro-alimentare (specialmente i bovini), gli animale da ricreazione (tipicamente il cavallo).
Per quel che riguarda i farmaci, da decenni le ricerche di screening di nuovi composti naturali o artificiali si conducono su colture di cellule e su sistemi molecolari; e paradossalmente, l’altra categoria soggetta a sperimentazione è la specie umana, secondo severe regole internazionali che tutelano il paziente informato. Gli effetti di una proibizione della sperimentazione animale sarebbero gravi dal punto di vista delle conoscenze sulle basi biologiche delle malattie e della loro cura. I cosiddetti “metodi alterativi” sono già stati altamente sfruttati: le cellule in vitro per gli screening delle sostanze non ancora investigate e scoperte o sintetizzate di recente e le simulazioni informatiche per cercare di inferire i meccanismi esistenti che presuppongono comunque possibilità di verifica concreta. Si potrebbe semmai mirare a diminuire ulteriormente il numero di animali in totale utilizzati, grazie ad una migliore “parametrizzazione” degli effetti, ed a migliorare le competenze dei comitati etici che per legge devono verificare e autorizzare l’utilizzo degli animali nelle ricerca scientifica
Cellule di mammifero in coltura che crescono come colonie sul fondo di una piastra di plastica. Il metodo è disponibile dal 1956, messo a punto da Puck et al., ed è stato ampiamente usato. Le tre piastre sono state seminate con lo stesso numero di cellule per piastra ma sono state trattate con diverse dosi di un agente nocivo che hanno avuto effetti diversi sulla vitalità cellulare.
Umberto Veronesi, da lungo tempo vegetariano primariamente per ragioni etiche nei riguardi degli animali, ha candidamente dichiarato (Corriere della Sera, 2 gennaio 2014) che è necessario per “ … migliorare il benessere … scegliere il male minore … accettando la sperimentazione animale nei casi in cui è ancora indispensabile … convinto che il mondo dovrà convertirsi al vegetarianismo per sopravvivere”.
Questo per la ricerca mentre ben diverso è il problema del numero di animali utilizzati per i controlli, dove potrebbe esserci lo spazio per una consistente diminuzione dei controlli stessi a patto che ciò sia reso possibile dalla normativa.
La necessità di trovare un compromesso sulla ”vexata quaestio” del trattamento degli animali si scontra purtroppo con una serie di gravi ignoranze o conoscenze distorte radicate nell’opinione pubblica, nei media e nei politici di entrambi gli ipotetici schieramenti. E’ quasi ignota al grande pubblico una serie rilevante di informazioni riguardanti:
- la definizione classica di specie (senza la quale la stessa accusa di specismo non potrebbe essere discussa) e la sorprendente coincidenza tra i dati della biologia molecolare e quelli della genetica classica,
- gli elementi basati sul concetto di specie: la classificazione tassonomica degli esseri viventi, l’evoluzione biologica, una visione moderna del neo-darvinismo superando ogni concezione erronea di “darwinismo sociale;
- il concetto di biodiversità (non solo genetica e specifica, ma ecosistemica e paesaggistica) con particolare attenzione al livello ecosistemico che sembra essere il più importante per l’adattamento;
- il ruolo degli aspetti comportamentali,
- i meccanismi e l’entità dei rapporti tra specie (fenomeni del parassitismo, commensalismo, inquilinismo, simbiosi),
- il fenomeno della domesticazione (di animali, piante e microorganismi),
- la storia dell’uomo nella preistoria e del suo rapporto con la natura fino all’oggi;
- i meccanismi d’azione degli agenti nocivi (compresi molti farmaci);
- l’utilizzo di parametri come la durata della vita a fini di comparazione biologica: ecc.
Come pure sono elementi ignoti o quasi le elaborazioni dell’etica, la definizione di “essere senziente”, i metodi di divulgazione e informazione scientifica e persino i metodi di negoziazione.
Chi scrive non ha soluzioni da proporre, ma è convinto che un compromesso dovrà essere trovato e che dovrà essere tollerata l’introduzione di una quasi impossibile tolleranza. Nel frattempo, sgombrare il campo da incomprensioni, errate percezioni o informazioni non corrette, potrebbe essere utile, nella convinzione un po’ fuori moda che la conoscenza è sempre meglio dell’ignoranza.

